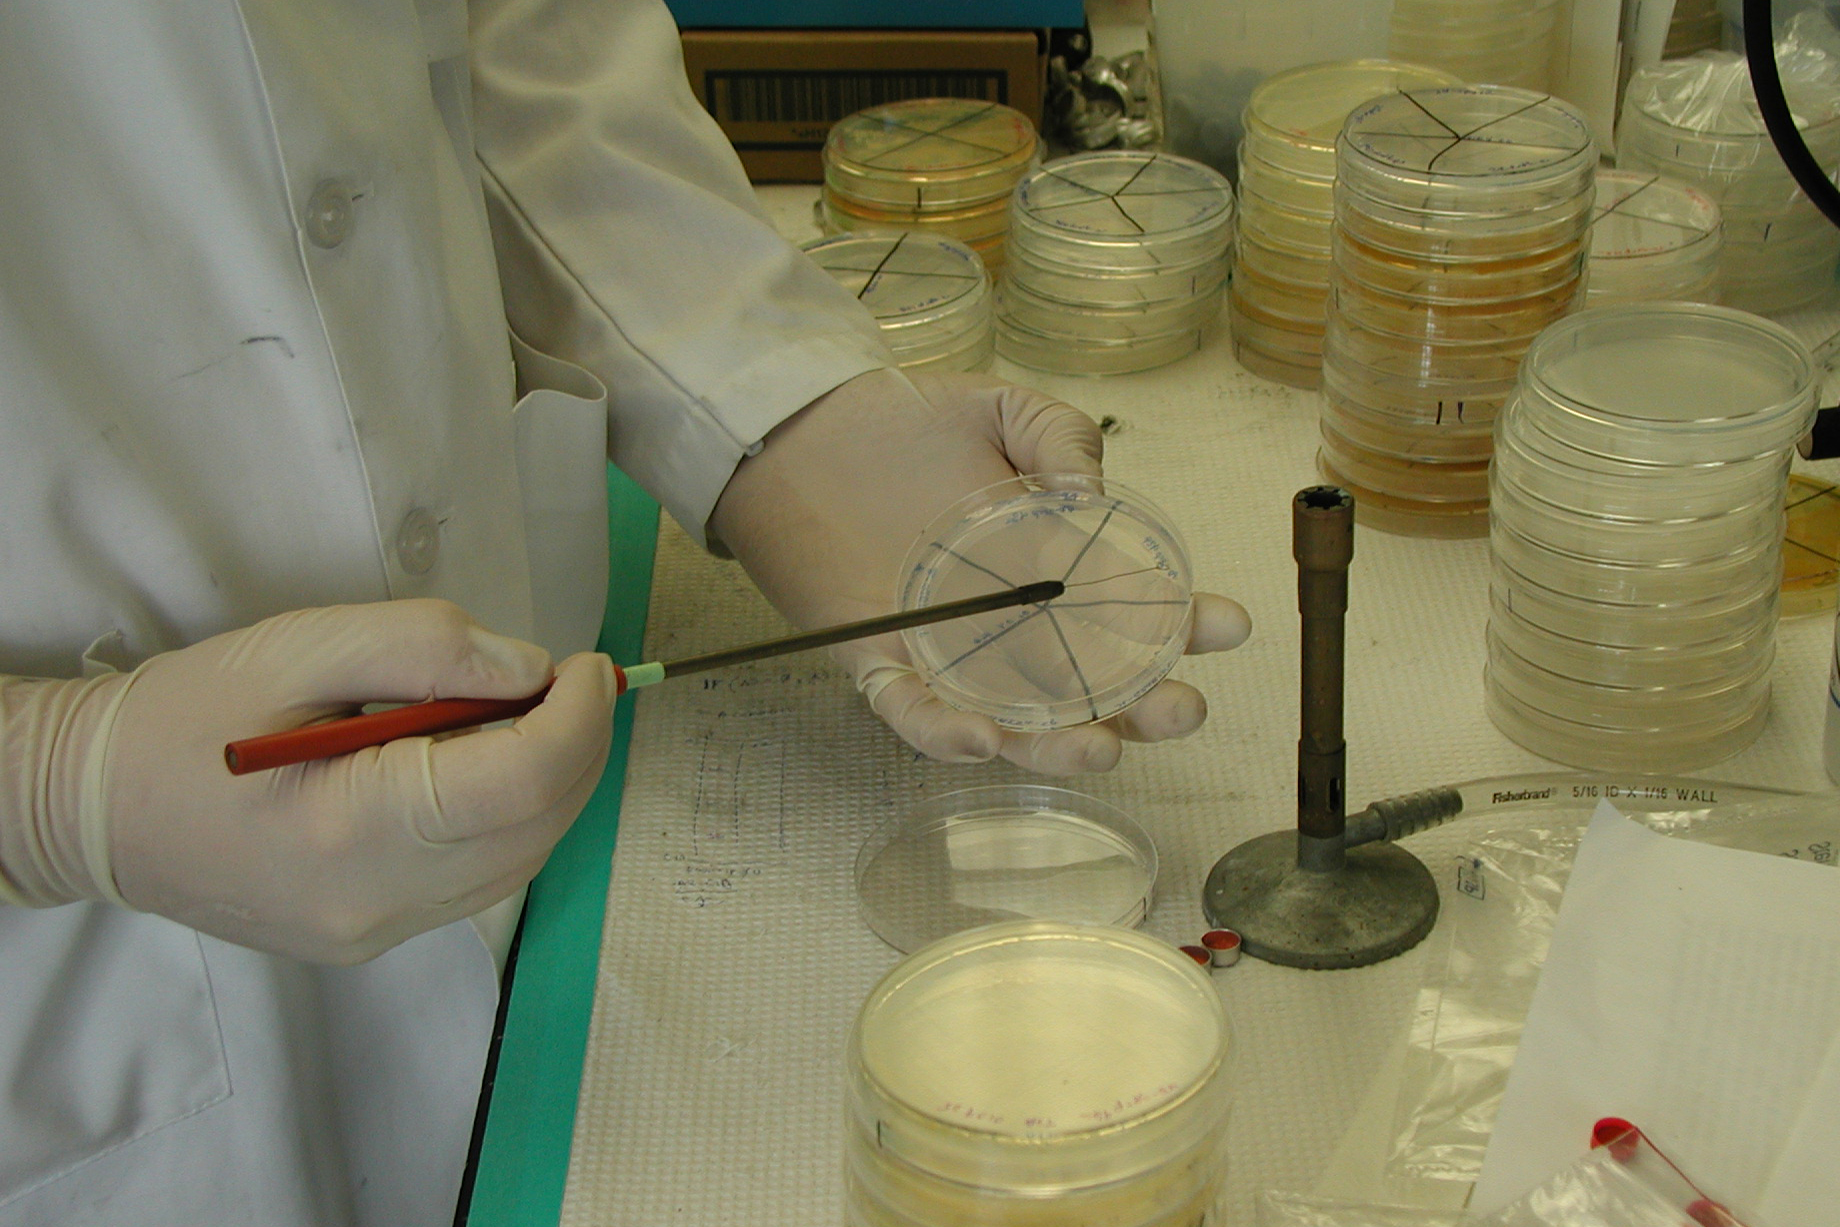

Body
Program Description
The Microbial Biology program is for students interested in understanding and exploiting microbes and their activities. Students receive an excellent education on the genetic, metabolic, physiologic, and evolutionary diversity of microorganisms and their role in sustaining our biosphere and influencing our health and well-being. Our program prepares students for research, education, and policy positions in academia, industry, and government.
Explore Rutgers Department of Biochemistry and Microbiology
Degree Types
- M.S. (Master of Science)
- Ph.D. (Doctor of Philosophy)
Campus Locations
Busch Campus - New Brunswick
Cook/Douglass Campus - New Brunswick
Admission Deadlines
For best consideration apply by these dates
| Application Type | US Applicants | Non-US Applicants | Merit-Based Aid |
|---|---|---|---|
| Ph.D. | December, 15 | December, 15 | December, 15 |
| MS | April, 1 | April, 1 |